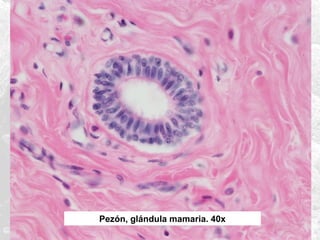
Pezón, glándula mamaria. 40x

Este documento describe las características generales del tejido epitelial. Explica que los epitelios están compuestos de células muy cercanas que cubren el cuerpo y los órganos. Se clasifican según su forma y número de capas celulares. Cumplen funciones como protección, secreción, absorción y sensibilidad. Los principales tipos son el epitelio simple plano, cúbico y cilíndrico, así como el estratificado plano y cilíndrico.